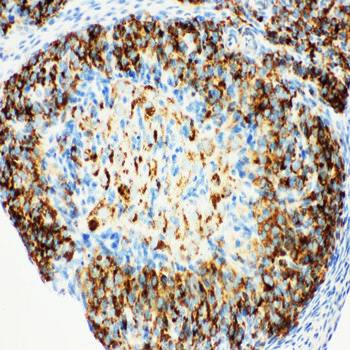
HSD17B1 Rabbit Polyclonal Antibody

You have no items in your shopping cart.
Estradiol
Description
Research Area
Images & Validation
−
Key Properties
−| CAS Number | 50-28-2 |
|---|---|
| MW | 272.38 |
| Purity | >99.99% (May vary between batches) |
| Formula | C18H24O2 |
| SMILES | C[C@@]12[C@]([C@]3([C@@](C=4C(CC3)=CC(O)=CC4)(CC1)[H])[H])(CC[C@@H]2O)[H] |
| Target | Estrogen Receptor/ERR,Estrogen/progestogen Receptor,Endogenous Metabolite |
| Solubility | Ethanol:20.4 mg/mL (74.9 mM);DMSO:250 mg/mL (917.84 mM);10% DMSO+40% PEG300+5% Tween 80+45% Saline:2.73 mg/mL (10.02 mM) |
Bioactivity
−| Target IC50 | |
|---|---|
| In Vivo | |
| In Vitro | |
| Cell Research |
Storage & Handling
−| Storage | keep away from direct sunlight,store under nitrogen | Powder: -20°C for 3 years | In solvent: -80°C for 1 year | Shipping with blue ice/Shipping at ambient temperature. |
|---|---|
| Expiration Date | 12 months from date of receipt. |
| Disclaimer | For research use only |
Alternative Names
−Similar Products
−Phospho-Estrogen Receptor alpha (Ser118) Recombinant Rabbit Monoclonal Antibody [orb559110]
FC, ICC, IF, IHC-Fr, IHC-P, WB
Canine, Rabbit, Rat
Human, Mouse, Rat
Rabbit
Recombinant
Unconjugated
50 μl, 100 μlEstrogen Receptor alpha + beta Rabbit Polyclonal Antibody [orb10615]
FC, ICC, IF, IHC-Fr, IHC-P, WB
Mouse, Porcine
Human, Rat
Rabbit
Polyclonal
Unconjugated
50 μl, 100 μl, 200 μlHSD17B1 Rabbit Polyclonal Antibody [orb137855]
ICC, IHC, WB
Human, Rat
Rabbit
Polyclonal
Unconjugated
100 μgEstrogen Receptor α (ready to use) Mouse Monoclonal Antibody [orb544741]
ICC, IF, IHC-Fr, IHC-P
Human
Mouse
Monoclonal
Unconjugated
6 ml, 3 mlEstrogen Receptor alpha Rabbit Polyclonal Antibody [orb13402]
FC, ICC, IF, IHC-Fr, IHC-P
Gallus, Mouse, Porcine, Sheep
Human, Rat
Rabbit
Polyclonal
Unconjugated
50 μl, 100 μl, 200 μl

Quality Guarantee
Explore bioreagents carefree to elevate your research. All our products are rigorously tested for performance. If a product does not perform as described on its datasheet, our scientific support team will provide expert troubleshooting, a prompt replacement, or a refund. For full details, please see our Terms & Conditions and Buying Guide. Contact us at [email protected].
Compound Identifiers
Key Properties
−Documents Download
Request a Document
Protocol Information
Estradiol (orb1309940)
Participating in our Biorbyt product reviews program enables you to support fellow scientists by sharing your firsthand experience with our products.
Login to Submit a Review